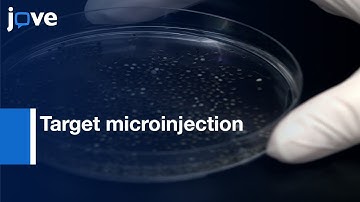
Target microinjection to developing Kidney | Protocol Preview

⬇ DOWNLOAD NOW
Kalau muncul iklan pop-up, tutup lalu klik tombol kembali
Download lagu Xenopus Oocytes:Microinjection/Removal-Follicular Cell Layer/Fast Solution Change l Protocol Preview secara gratis hanya untuk keperluan promosi. Dukung artis favorit kamu dengan membeli musik original di iTunes atau platform resmi lainnya.
 Microinjection: Xenopus Laevis Oocytes l Protocol Preview
Microinjection: Xenopus Laevis Oocytes l Protocol Preview
 Frog oocyte microinjection
Frog oocyte microinjection
 Visualizing RNA Localization In Xenopus Oocytes l Protocol Preview
Visualizing RNA Localization In Xenopus Oocytes l Protocol Preview
 Patch Clamp Recording: Ion Channels Expressed In Xenopus Oocytes l Protocol Preview
Patch Clamp Recording: Ion Channels Expressed In Xenopus Oocytes l Protocol Preview
 Functional Cloning Using Xenopus Oocyte Expression System l Protocol Preview
Functional Cloning Using Xenopus Oocyte Expression System l Protocol Preview
 Microinjection of Xenopus Laevis Oocytes
Microinjection of Xenopus Laevis Oocytes
Target microinjection to developing Kidney | Protocol Preview
Target microinjection to developing Kidney | Protocol Preview
 Patch Clamp & Perfusion Techniques: Ion Channels Expressed-Xenopus oocytes l Protocol Preview
Patch Clamp & Perfusion Techniques: Ion Channels Expressed-Xenopus oocytes l Protocol Preview